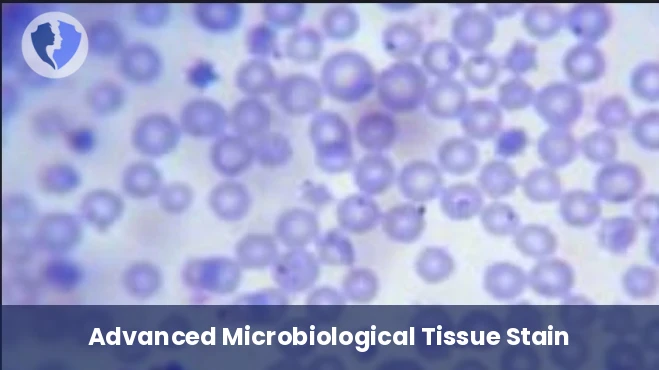
Giemsa Special Stain

Service Details
Giemsa Special Stain
Gemsa is a complex dye composed of methylene blue and eosin, used in microbiology and histology. It stains acidic components (such as cell cytoplasm and some bacteria) red to pink and basic components (such as cell nuclei, parasite DNA, and some bacteria) blue to violet. It is the preferred method for detecting malaria parasites in both thick and thin blood smears.